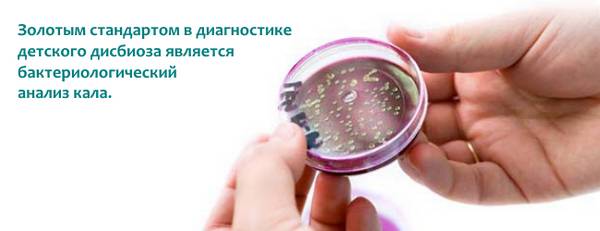
image

Содержание
Симптоматика дисбактериоза кишечника
Многих пациентов интересует, как выявить дисбактериоз самостоятельно и в каком случае стоит обращаться к врачу. К сожалению, распознать первые признаки заболевания очень трудно. В течение нескольких дней патология протекает бессимптомно. Если лечение не проводится, количество патогенных микробов значительно увеличивается. Тогда состояние больного значительно ухудшается, и возникают первые признаки заболевания.
Как проявляется дисбактериоз в кишечном канале? Этот патологический процесс имеет много признаков, и все они имеют схожесть с другими заболеваниями. К основным проявлениям принято относить развитие поноса или длительного запора, общее недомогание, тошнота, болевое чувство в животе и спазмы.
Симптомы дисбактериоза кишечника у женщин могут проявляться:
- в изменении характера выделений. Они могут стать более жидкими или густоватыми. При этом оттенок может также изменяться;
- нарушение менструального цикла;
- болевое чувство в области поясницы и живота в нижней области;
- если говорить о будущих мамах, то у них тоже нередко развивается дисбактериоз на фоне изменений в гормональном фоне. Тогда признаки дисбактериоза кишечника у женщин на этапе вынашивания будут проявляться в следующем:
- незначительное повышение температурных показателей;
- сонливость, общая ослабленность;
- спазмы в кишечном канале;
- длительные запоры;
- появление аллергических реакций в виде высыпаний на кожном покрове, зуде;
- вздутость живота, отрыжка и изжога.
У мужчин при дисбактериозе кишечника может нарушиться функциональность предстательной железы. На фоне этого нередко развивается импотенция и простатит. Также начинает страдать мочевой пузырь. Позывы к посещению туалета становятся все чаще. При этом возникает боль.
Боли при дисбактериозе могут иметь абсолютно разный характер — ноющий, тупой, режущий, колющий, постоянный и периодический. Поэтому если у пациента наблюдаются вышеперечисленные симптомы, то надо немедленно обратиться к доктору.
Показания к исследованию дисбактериоза кишечника
Какой врач лечит дисбактериоз кишечника? Не каждый знает, куда стоит обращаться при развитии неблагоприятных симптомов. Для начала достаточно обратиться к терапевту. Он выслушает жалобы больного и назначит ряд анализов. При подтверждении диагноза пациента отправляют к гастроэнтерологу. Именно он занимается проблемами желудочно-кишечного тракта.
Если наблюдается дисбактериоз кишечника, причины должны выявляться как можно скорее.
Показаниями к исследованию на патологический процесс являются:
- длительное применение антибактериальных и противомикробных средств;
- развитие аллергических реакций;
- появление высыпаний на кожном покрове;
- непереносимость отдельной продукции;
- болезненные ощущения в абдоминальной зоне;
- вздутость живота и метеоризм;
- длительные поносы или запоры;
- кровоточивость десен;
- наличие в каловых массах остатков переваренной пищи или слизи;
- повышенная ломкость волос и ногтей;
- появление беловатого налета на языке;
- потемнение эмали;
- понижение иммунных сил.
Чтобы определить тип бактериальной инфекции, надо пройти анализ кала и копроскопию.
Методы диагностирования кишечника
Самым достоверным способом у взрослых является анализ кала на бактериальный посев. Данная методика осуществляется при помощи катализатора. Приблизительно четыре-пять дней бактериальные агенты размножаются. За это время их рассматривают под микроскопом и высчитывают, сколько их приходится на один грамм взятого материала. Результат анализа производится в КОЕ/грамм.
Чтобы бактериологическая диагностика дисбактериоза кишечника показала верный результат, надо придерживаться некоторых правил перед выполнением анализа на кал.
- За три дня до обследования нужно убрать из меню рыбные и мясные блюда, а также спиртные напитки. Они вызывают процессы брожения в кишечном канале.
- В течение трех дней до анализа кала нельзя употреблять никакие лекарственные средства в виде антибиотиков, ректальных свечей, вазелинового и касторового масла.
- Перед тем как сдать анализ кала, нужно подмыть под проточной водой промежность.
- Каловые массы должны быть получены только естественным путем без использования клизм и слабительных средств.
- Важно проследить за тем, что в кале не было капелек мочи, иначе результат будет недостоверным.
- Материал собирается в специальную стерильную баночку, которая продается в аптечных киосках.
- Чтобы результат исследования оказался правильным, необходимо собирать кал в горячую пленку или стерильное судно.
- Если в каловых массах присутствует кровь или слизь, то обязательно нужно провести копрограмму.
- Количество материала не должно быть меньше десяти грамм.
- Время доставки каловых масс до лаборатории не должно превышать двух часов. Чем раньше пациент сдаст материал, тем вернее будет результат.
У взрослых собирать кал гораздо проще, чем у ребенка. Если диагностика производится у малыша, то сначала нужно, чтобы он помочился. В стерильную емкость также собирается около десяти грамм кала.
При дисбактериозе кишечника могут быть обнаружены разные бактерии, но их содержание имеет определенную норму:
Количество клостридий составляет 103-105 КОЕ/грамм.
- Количество стрептококков составляет 105-10КОЕ/грамм.
- Эшерихий в организме содержится 106-108 КОЕ/грамм.
- Бифидобактерий в кишечном канале располагается 108-110 КОЕ/грамм.
- Кишечная палочка со сниженной ферментативной активностью не должна превышать 104 КОЕ/грамм.
Если уровень не соответствует норме, то принято говорить о нарушении микрофлоры кишечника.
Советы специалистов
Бактериологический анализ хронического дисбактериоза дает возможность исследовать содержимое кишечного тракта и определить живущих в нем бактерий. Но этот метод обследования имеет несколько минусов.
- Анаэробные бактерии гибнут при контактировании с кислородом, что искажает точность результатов.
- Не учитываются бактериальные агенты мукозного характера. Они проживают на слизистой оболочке толстой кишки и не попадают в каловые массы.
Сдать анализ на дисбактериоз кишечника при помощи биохимического исследования гораздо эффективнее и быстрее. Бактериальные агенты выявляют жирные кислоты, в результате чего и происходит сбой в работе органа.
Сколько делается анализ на дисбактериоз? Результат после осуществления биохимического метода исследования будет известен уже через один час. При этом удается распознать полостную и мукозную флору. Данные будут гораздо точнее, а подготовки никакой не требуется.
Дисбактериоз кишечника при беременности ведет ко многим проблемам. Поэтому биохимический анализ каловых масс позволит не только выявить причину недуга, но и состояние слизистой оболочки пищеварительного канала.
Как сдавать анализ у взрослых женщин? Существует несколько важных рекомендаций:
- За три-четыре дня необходимо отказаться от применения слабительных средств.
- Если возник дисбактериоз кишечника после антибиотиков, то анализ надо пройти только через 10-14 дней после приема последней таблетки.
- Для взятия материала не нужно использовать клизму. Хранить надо в специальной таре, которую можно приобрести в аптеке.
- Каловые массы не должны содержать капли мочи и выделений женщины.
- Сдать материал необходимо в течение трех часов. Плюс метода в том, что кал можно замораживать до следующего дня.
Кишечная палочка с нормальной ферментативной активностью уничтожает патогенную флору. При исследовании материала количество энтеробактерий должно быть сведено к нулю. Если говорить про общее количество кишечной палочки, то оно находится в пределах 400-1 млрд/грамм.
Влияние на результаты исследования
Если пациенту назначают такие методики диагностирования, то стоит учитывать некоторые факторы. При несоблюдении рекомендаций доктора показатели микрофлоры меняются, что может привести к неверному результату.
Вот несколько из них.
- В кишечном канале постоянно располагаются мукозные бактерии. Выявить их наличие очень трудно, так как они располагаются на кишечных стенках, поэтому при проведении бактериологического исследования их не видно. Если причину не удалось выявить, то повторно выполняют биохимический анализ.
- Каловые массы не должны долго контактировать с воздухом, иначе результат обследования будет искажен. Чтобы этого не произошло, кал должен незамедлительно помещаться в контейнер и накрываться крышкой.
- Несоблюдение диеты также сказывается на результатах. Если употреблялись жирные блюда, мясо, рыба, алкоголь, то показания будут размытыми. На фоне этого диагноз будет поставлен неверно.
- Если материал будет доставлен позже положенного срока, то некоторых бактерий вообще не получится обнаружить. Чем кал свежее, тем результаты вернее.
Лечение дисбактериоза кишечника начинает проводиться только после диагностики. Если диагноз подтвержден, то пациенту прописывают целый список лекарственных средств. Самостоятельно принимать медикаменты не стоит, так как это может только ухудшить состояние больного и привести к осложнениям. При отсутствии эффекта нужно снова посетить врача.
Советы и рекомендации
Частые вопросы
Как проводится анализ на дисбактериоз кишечника?
Анализ на дисбактериоз кишечника проводится путем сбора фекалий и последующего изучения микрофлоры кишечника на наличие и количество различных видов бактерий.
Когда необходимо проводить анализ на дисбактериоз кишечника?
Анализ на дисбактериоз кишечника рекомендуется проводить при наличии симптомов, таких как нарушение стула, боли в животе, вздутие, аллергические реакции, а также после приема антибиотиков или при подозрении на нарушение микрофлоры кишечника.
Полезные советы
СОВЕТ №1
Не забывайте о подготовке к анализу на дисбактериоз кишечника. Важно соблюдать рекомендации врача относительно диеты и приема лекарств, чтобы результаты были максимально точными.
СОВЕТ №2
Обратитесь к квалифицированному специалисту для интерпретации результатов анализа. Только профессионал сможет правильно оценить данные и поставить диагноз.
СОВЕТ №3
Не забывайте, что анализ на дисбактериоз кишечника может быть полезен не только при наличии симптомов заболевания, но и для контроля состояния микрофлоры после курса антибиотиков или других лечебных мероприятий.